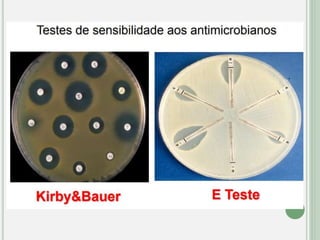
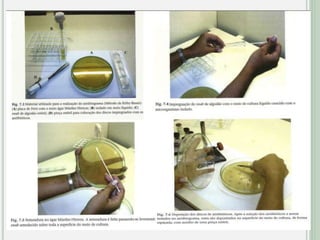

O documento discute os principais tipos de antibióticos, incluindo β-lactâmicos, glicopeptídeos, macrolídeos, aminoglicosídeos e fluoroquinolonas. Ele explica como cada classe funciona, suas indicações terapêuticas e efeitos adversos. O documento também aborda resistência bacteriana e mecanismos de ação dos antibióticos.





![RESISTÊNCIA BACTERIANA
São capazes de se multiplicar em [ ] altas de
antimicrobianos;
Resistência
Intrínsica Adquirida](https://image.slidesharecdn.com/princpiosgeraisdousodeantibacterianos-240327235135-fd63f311/85/Principios-Gerais-do-uso-de-Antibacterianos-6-320.jpg)